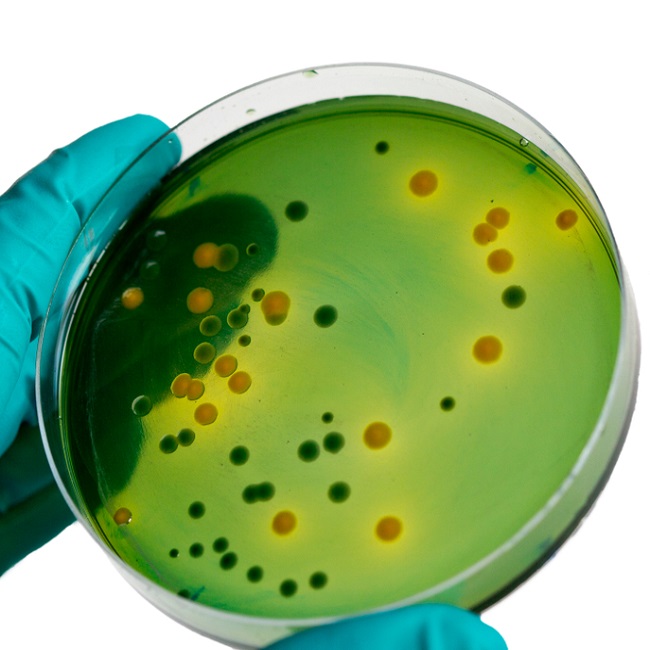

CATEGORIES
- Digital Marketing & Creative Services
- IT & Technical Services
-
Professional Services & Business Support
Education & Tutoring Academic Tutoring (e.g., Math, Science, Languages) Test Preparation (e.g., SAT, ACT, GRE) Training Services
- Personal Styling & Event Services
-
Products & Goods Supplies Services
Consumer Goods Marketing Packaged Foods & Beverages Beauty & Personal Care Products Household Essentials & Cleaning Products Baby, Kids & Family Products Fashion & Accessories (Clothing, Shoes, Jewelry) Electronics & Gadgets View more...Industrial Goods Promotion Machinery & Heavy Equipment Tools & Hardware Industrial Chemicals Safety & Protective Equipment Construction MaterialsAgricultural & Agro-Allied Products Fresh Farm Produce Processed Agricultural Products Seedlings, Fertilizers & Agrochemicals Farming Tools & Equipment Livestock & Animal FeedHealth & Medical Supplies Marketing Pharmaceuticals & Medications Medical Devices & Equipment Wellness & Nutritional Products Hospital ConsumablesEducational & Stationery Products Books & Publications Office, School & Home Stationery Educational Aids & Learning Kits School SuppliesArt, Decor & Lifestyle Goods Handcrafted & Artistic Products Home/Office Decor & Furnishings Cultural & Traditional Items Luxury Goods & CollectiblesAutomotive Parts & Accessories Auto Spare Parts Tyres & Batteries Vehicle Electronics & Audio Systems Vehicle Cleaning & Maintenance ProductsTech & Smart Devices Mobile Phones & Accessories Smart Devices Wearable Tech Computers, Accessories & PeripheralsEnergy & Utility Products Solar Panels & Inverters Generators & Power Equipment Gas Cylinders & Accessories Energy-saving Devices
- All Businesses
- All Categories
Industries
NWpOWHp1OFFTcVJWcTVtUGxYWTdUNlVFRUtyY00xZWYxeEt3QWxnaEJlK2RldGswRCt4V0FmVk1PZVFIOVpYeUVYeUtPZ09OUGlxaXN3V3llMFdlQVNwVWhXd2hCZz09NDAxNWQ5MWIxMjJiNmRjOGMzOWEzOGY4NmFmZWIwNGIxYTg0MTNhMmE3MjYyMDBkNzU2N2U3MDczMw==
NWpOWHp1OFFTcVJWcTVtUGxYWTdUNlVFRUtyY00xZWYxaHVkQW5RWFU3Yk1KYlpjWllGUUFlOVJLN1pLdDh1M1NuS1Nia3pGWm1ucXFRdTBld0E9NDAxNWQ5MWIxMjJiNmRjOGMzOWEzOGY4NmE4MTFlMjU2NDAyMTY5ZjVlYTM1OTgwMTYxZTlhNzk5ZQ==
NWpOWHp1OFFTcVJWcTVtUGxYWTdUNlVFRUtyY00xZWYxeEt3QWtZdEVmS1ZjK01ZRCt3NGFmeEtNZUlDOEpmM0JHZUtjMW1ZTHlpeTQwYWhka3lZQ1N4VGdHTWlUSnJONDAxNWQ5MWIxMjJiNmRjOGMzOWEzOGY4NmFhODVhYWY3ZTcwMWVkODZmYWZiNzBlM2I0NGIzNWUxMg==